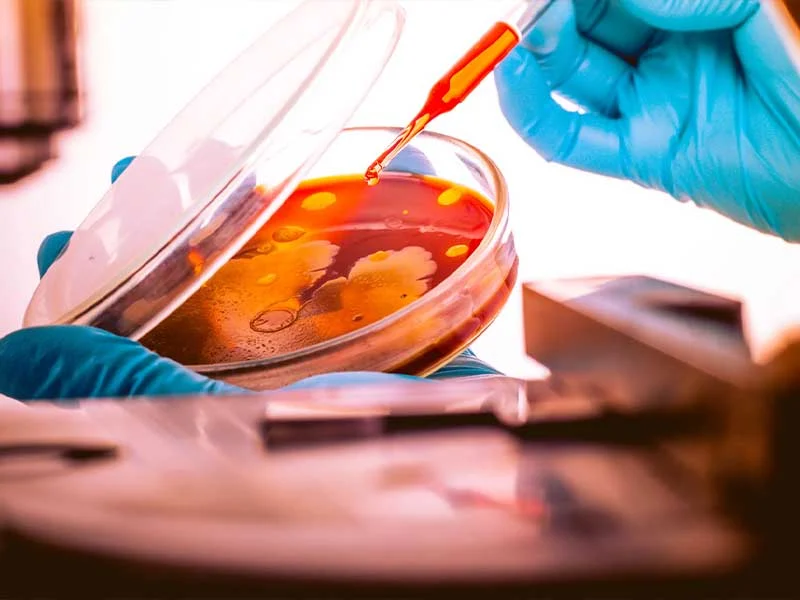

Precise cooling for demanding materials
BBA Coolers are used wherever materials need to be solidified and comminuted in a controlled manner. Every application has its own specific requirements in terms of cooling speed, particle size, and product purity. Our machines provide the right process solution, from laboratory scale to large-scale industrial production.
Find your application
Fine & Specialty Chemicals
Drawing on its extensive experience, BBA Cooling Technology develops reliable process solutions for complex applications in the fine and specialty chemicals industry, such as the processing of waxes and polymers of various consistencies and formulations.

Life Science & Food
BBA Cooling Technology develops innovative process solutions for the life sciences and food industries that meet the highest quality standards and adapt flexibly to dynamic market and production conditions.

Pharmaceuticals
For the pharmaceutical industry, BBA Cooling Technology offers GMP-compliant process solutions for continuous production using HME, ensuring the highest quality standards, process reliability, and efficiency.


